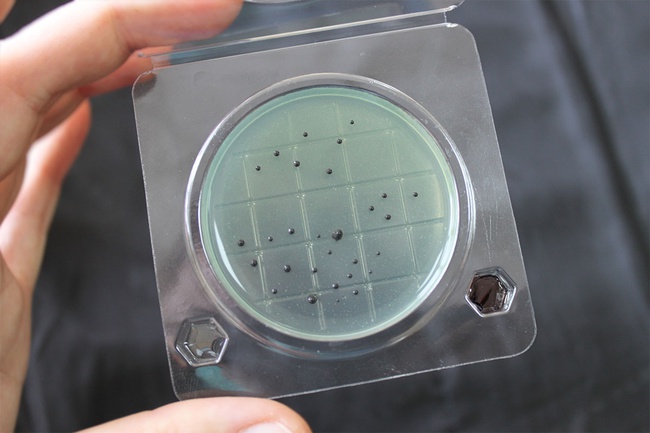
&quot;Petritest&quot; (substrat) Salmonella

Mevcut
1.48
USD/adet
Minimum sipariş: 10 pcs
Sevkiyat kapasitesi: 300 pcs/günde
ООО НПО Альтернатива
Doğrulanmamış tedarikçi
Rusya
Nakliye bilgileri
Qoovee Logistics ile dünyanın herhangi bir yerine kargo taşımacılığı hesaplayın ve gerçekleştirin.
Zamanında sevkiyat garantisi ve ödeme güvenliği Qoovee'den teslimatı hesaplayınBenzer ürünler
Tedarikçiler kategorisi
Tüm tedarikçi kategorileriTedarikçiye sor
Tedarikçi:
"Узлегпром"
Ürün:
Tedarikçi:
Min. sipariş:
Dizin
Pazarlama departmanı:
Pazarlama departmanı:
Pazarlama departmanı:
Bilgi
Ürünü Qoovee'de bulduğunuzu bize bildirin
Tedarikçinin iletişim bilgileri kapalı !
Tedarikçiye yaz